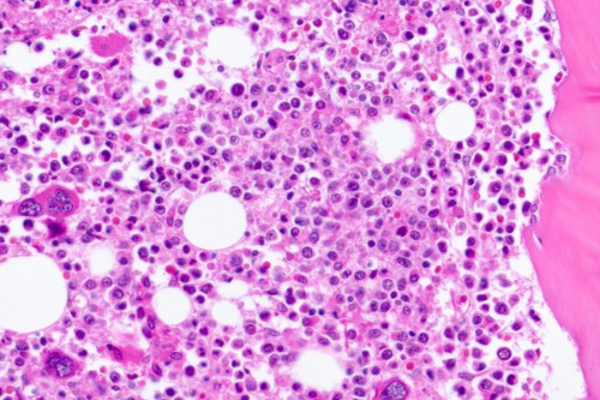

Xơ tủy nguyên phát (Primary Myelofibrosis - PMF) là một rối loạn tăng sinh tủy mạn tính. Bệnh đặc trưng bởi thiếu máu, lách to, tế bào hạt không trưởng thành, nguyên hồng câu và các hồng cầu hình giọt nước trong máu, xơ tủy và xơ cứng xương. Bệnh có thể xảy ra ở mọi lứa tuổi, thường gặp ở người hơn 50 tuổi.